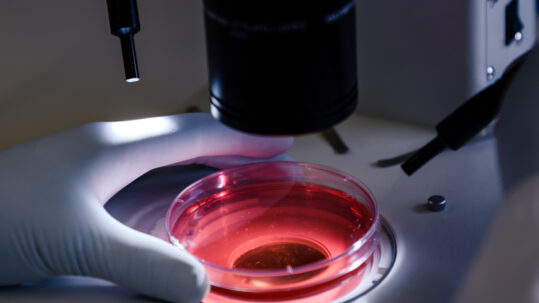

FERTILITY DOCTOR MISCONDUCT
Regularly, the fertility lawyers at Peiffer Wolf are contacted by families who discover shockingly disturbing DNA testing results. In many instances, families learn that their own fertility doctor is the biological father of their child or children. As more fertility center lawsuits are filed, families who have conceived through IVF and Assisted Reproductive Technology (ART) are growing concerned about the “behind-closed-doors” nature of the IVF process.
In many instances, the DNA tells a wildly different story than the fertility doctor. Unfortunately, DNA testing often directly contradicts what a fertility doctor has told his patients. We hear about fertility doctors who told parents that they were going to use anonymous sperm donations from medical students, only to find out that it was the doctor’s sperm. In other instances, we find couples who thought their own egg and sperm were being used to create embryos but later find out that it was the mother’s egg and the doctor’s sperm.
Now, families are turning to home DNA kits like 23andMe and Ancestry.com to search for answers. In many cases, the databases connect children with biological parents, as well as dozens of more distant genetic matches in their family tree. However, where many children expect to see their mother and father directly above them in that tree, they find their parent’s fertility doctor or a complete stranger.
Peiffer Wolf is nationally recognized for representing victims of reckless fertility clinics, including fertility doctor misconduct. If you or your family have been the victim of fertility doctor misconduct, please Contact the Fertility Lawyers at Peiffer Wolf for a FREE Consultation by filling out our online Contact Form or by calling 415-766-3545.